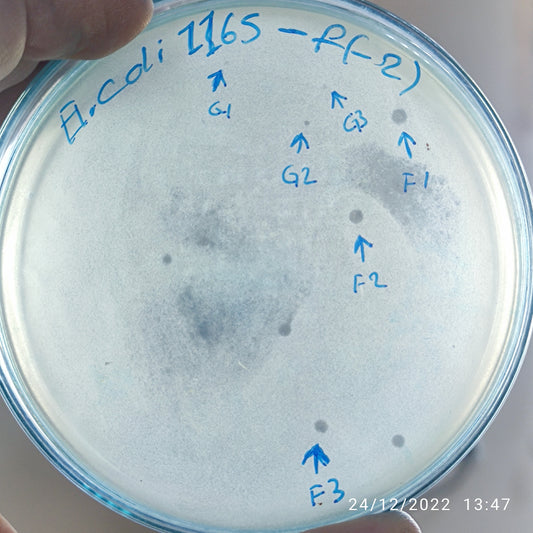
Escherichia coli bacteriophage 101165G
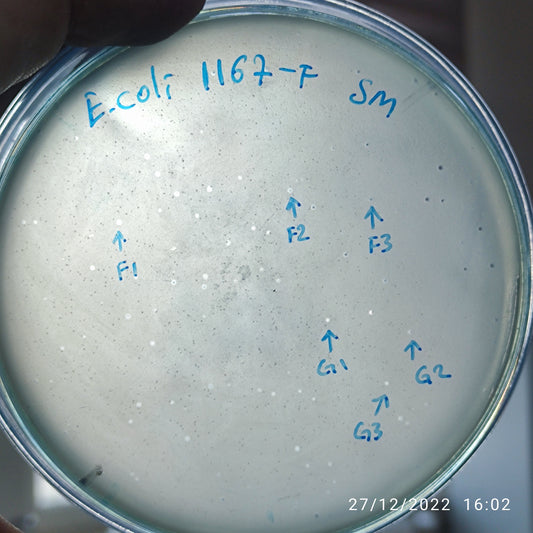
Escherichia coli bacteriophage 101167F
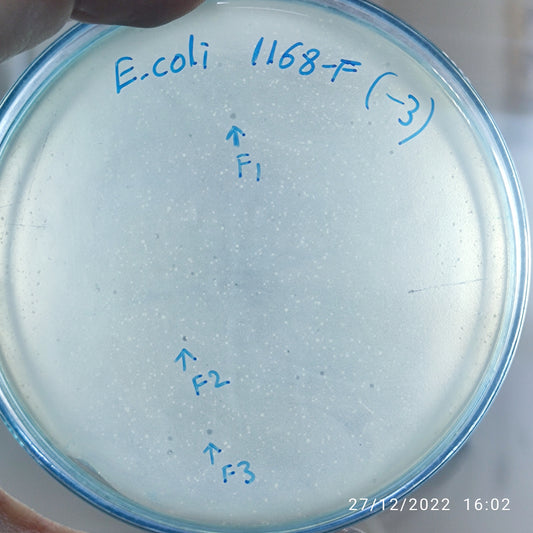
Escherichia coli bacteriophage 101168F
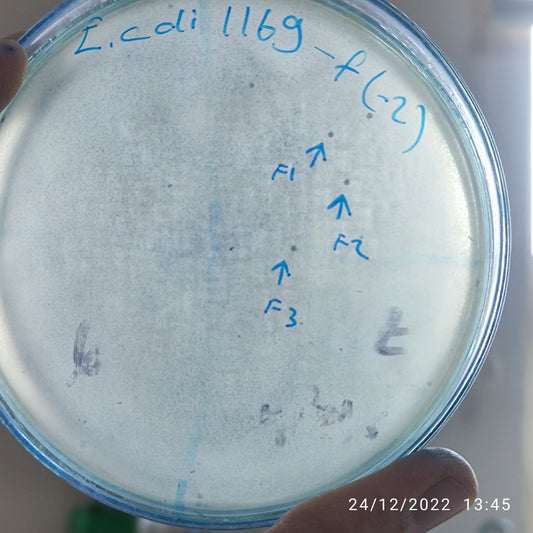
Escherichia coli bacteriophage 101169F
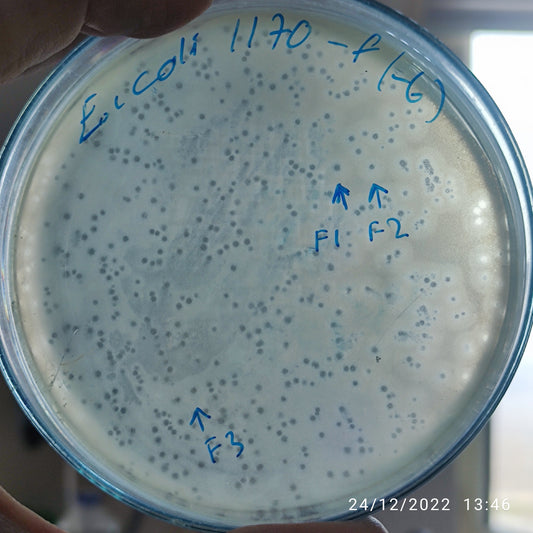
Escherichia coli bacteriophage 101170F
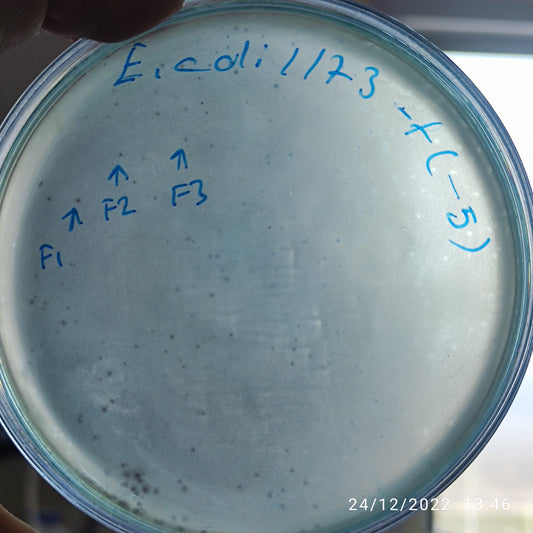
Escherichia coli bacteriophage 101173F
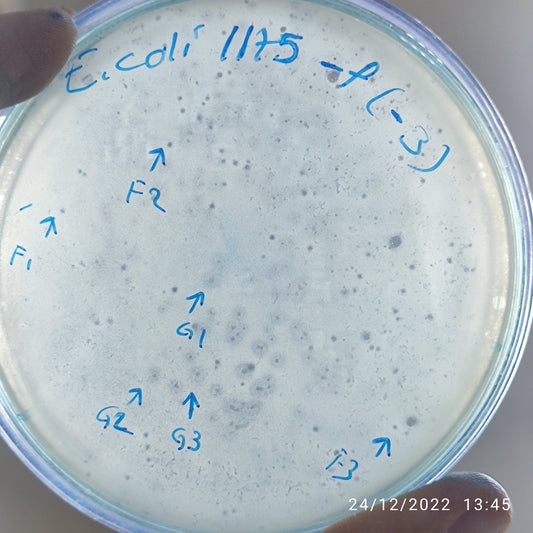
Escherichia coli bacteriophage 101175G
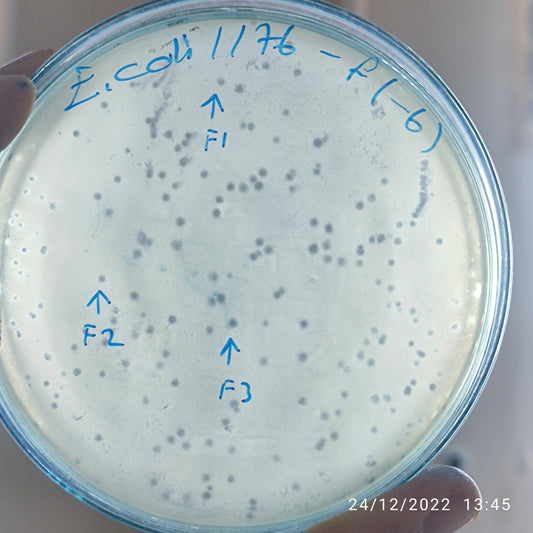
Escherichia coli bacteriophage 101176F
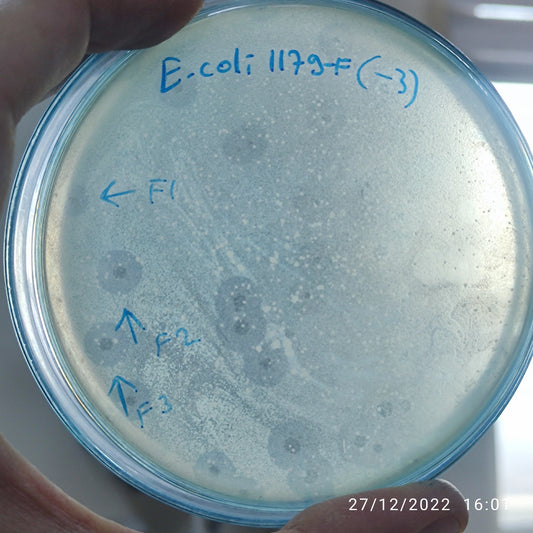
Escherichia coli bacteriophage 101179F

-
Escherichia coli bacteriophage 101165F
Regular price $500.00 USDRegular priceUnit price per -
Escherichia coli bacteriophage 101165G
Regular price $500.00 USDRegular priceUnit price per -
Escherichia coli bacteriophage 101166F
Regular price $500.00 USDRegular priceUnit price per -
Escherichia coli bacteriophage 101167F
Regular price $500.00 USDRegular priceUnit price per -
Escherichia coli bacteriophage 101167G
Regular price $500.00 USDRegular priceUnit price per -
Escherichia coli bacteriophage 101168F
Regular price $500.00 USDRegular priceUnit price per -
Escherichia coli bacteriophage 101169F
Regular price $500.00 USDRegular priceUnit price per -
Escherichia coli bacteriophage 101170F
Regular price $500.00 USDRegular priceUnit price per -
Escherichia coli bacteriophage 101172F
Regular price $500.00 USDRegular priceUnit price per -
Escherichia coli bacteriophage 101173F
Regular price $500.00 USDRegular priceUnit price per -
Escherichia coli bacteriophage 101175F
Regular price $500.00 USDRegular priceUnit price per -
Escherichia coli bacteriophage 101175G
Regular price $500.00 USDRegular priceUnit price per -
Escherichia coli bacteriophage 101176F
Regular price $500.00 USDRegular priceUnit price per -
Escherichia coli bacteriophage 101178F
Regular price $500.00 USDRegular priceUnit price per -
Escherichia coli bacteriophage 101178G
Regular price $500.00 USDRegular priceUnit price per -
Escherichia coli bacteriophage 101179F
Regular price $600.00 USDRegular priceUnit price per